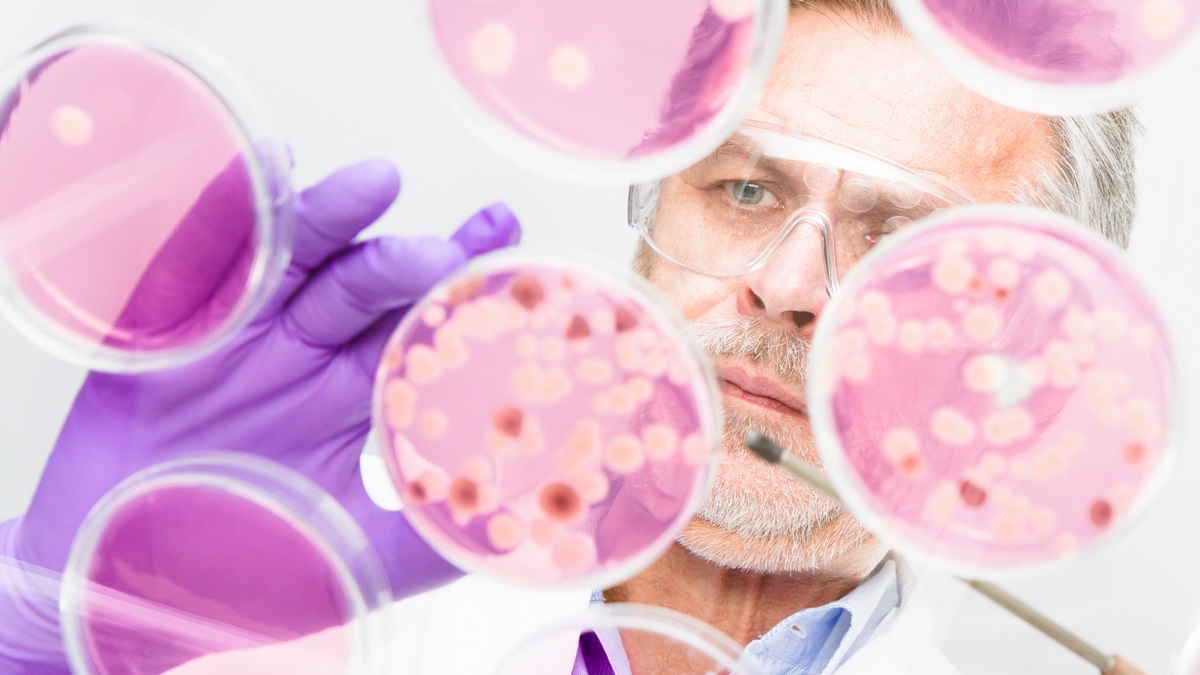
Skuteczność leczenia podtrzymującego blinatumomabem w ALL i LL po allogenicznej...

Ostre białaczki

5.06.2025
Hematoonkologia.pl
Aucatzyl: nowa nadzieja w terapii r/r B-ALL u dorosłych

22.04.2025
onkologia-dziecieca.pl, dr n. med. Igor Olejnik
Negatywność NGS-MRD w ostrej białaczce limfoblastycznej po przeszczepie komórek macierzystych

18.03.2025
Hematoonkologia.pl
Nowe algorytmy leczenia pierwszej linii dorosłych chorych na ALL

27.02.2025
Hematoonkologia.pl
Przypadek pacjentki, która rozwinęła nowotwór de novo po przeszczepie

11.12.2024
dr n. med. Paweł Kiciński
Długotrwała remisja ostrej białaczki limfoblastycznej Ph(+) u starszej pacjentki leczonej ponatynibem

13.11.2024
prof. dr hab. n. med. Agnieszka Piekarska
Skuteczność leczenia podtrzymującego blinatumomabem w B-ALL i LBL po allogenicznej transplantacji macierzystych komórek krwiotwórczych

22.07.2024
Hematoonkologia.pl
Prof. Agnieszka Wierzbowska: "Jesteśmy świadkami pojawiania się kolejnych przełomowych terapii w AML"

23.06.2024
Hematoonkologia.pl
Prof. Lars Bullinger o nowych metodach terapii ostrych białaczek

17.06.2024
Hematoonkologia.pl
Prof. Sebastian Giebel o najnowszych metodach terapii ostrej białaczki limfoblastycznej

10.06.2024
Hematoonkologia.pl
Prof. Agnieszka Wierzbowska o najnowszych doniesieniach w terapii AML

24.05.2024
lek. Aneta Nowicka
Dodanie maślanu zwiększa skuteczność wenetoklaksu w leczeniu ostrej białaczki szpikowej

24.04.2024
lek. Marta Masternak
Poprawa wyników przeszczepienia komórek macierzystych wśród pacjentów z AML powyżej 65. roku życia

22.04.2024
Hematoonkologia.pl